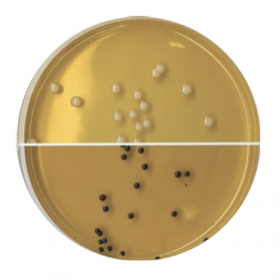
Агар Сабуро 200 мл
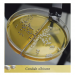
Агар Сабуро 200 мл

Агар Сабуро 200 мл
Агар Сабуро готовый к применению 200 мл
Питательная среда для выделения и культивирования дрожжеподобных и плесневых грибов при проведении бактериологических исследований в санитарной и клинической микробиологии.
Данный продукт предназначен для исследовательских целей.
Фасовка 200 или 400 мл.
Срок годности 1 год.
- Стерильность: +
- Форма выпуска: Раствор
- Упаковка: 200 мл
- Документы: Для исследовательских целей